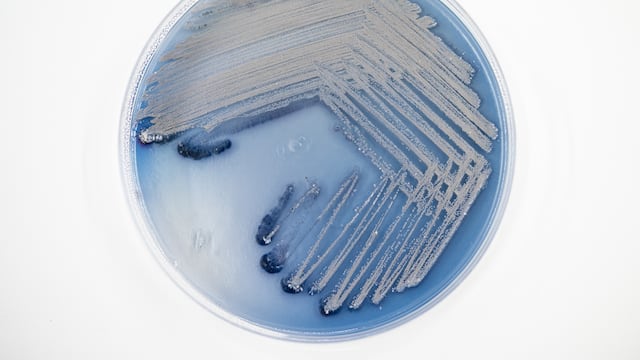

Aníbal Boscoboinik es un científico oriundo de Traslasierra que, hace algunos días, fue reconocido como el “Inventor del año” por Battelle, una organización que promueve la ciencia y la tecnología mundial. El químico habló con Vía Córdoba, detalló su invención y la importancia de la ciencia.
Boscoboinik nació en Villa Dolores, Córdoba. Cursó en la Escuela Normal Dalmasio Velez Sarsfield y a los 18 años, estudió la Licenciatura en Química en la Universidad Nacional de San Luis. Su carrera académica continuó con un doctorado en Estados Unidos y un postdoctorado en Alemania.
Actualmente, investiga en el Centro de Nanomateriales Funcionales del Laboratorio Nacional de Brookhaven, en Estados Unidos. Aún así, continúa relacionándose con la ciencia argentina y aportando sus conocimientos.
EL DESCUBRIMIENTO DE ANÍBAL QUE LO RECONOCIÓ COMO “INVENTOR DEL AÑO”
“Uno de sus inventos recientes se está aplicando a áreas importantes incluyendo la energía, la medicina, la no proliferación nuclear y la eliminación de contaminantes cancerígenos”, sostuvo Battelle cuando justificó el reconocimiento de Boscoboinik.
Es que, el científico traserrano y su hermano, Alejandro Boscoboinik, también químico, desarrollaron nuevos materiales y enfoques para separar gases no reactivos. “Descubrimos por accidente que los podíamos atrapar con el material con el que estabamos trabajando (...). Vimos que atrapaba argón y nos dio curiosidad; publicamos un artículo y nos empezó a contactar un montón de gente”, explicó Aníbal Boscoboinik.
Y ahondó: “Cerca del 20% de los casos de cáncer de pulmón, son por radón y no por fumar. No es muy fácil de solucionar este problema. Entonces, estamos explorando el poder atrapar el radón con este material que estamos estudiando”.
“Ésta es una de las aplicaciones, pero la que más impacto tendría sería la de hacer reactores más eficientes. Eso es más a largo plazo, dependiendo de gobiernos, y si la energía nuclear se usa o no. Pero estamos en la etapa exploratoria”, explicó el químico sobre lo palpable de su investigación.
LA IMPORTANCIA DE LA EDUCACIÓN PÚBLICA Y LA CIENCIA ARGENTINA
Aníbal Boscoboinik señaló que el reconocimiento le generó “una gran satisfacción” y valoró la importancia de la educación pública en su logro personal. “Hay un montón de argentinos que están afuera y a la mayoría, nos va bastante bien. Eso es algo que está relacionado con la calidad de la educación que tenermos en Argentina”, destacó.
“Cuando vine a mi doctorado, estaba mejor preparado que la mayoría de la gente de Estados Unidos”, diferenció y ponderó: “Si no fuera por la educación pública yo no estaría donde estoy. Es importantísimo y fundamental que la defendamos y expliquemos a los líderes su importancia”.

En el mismo sentido, destacó la importancia de la inversión en ciencia y señaló: “En Estados Unidos está bastante claro y gran parte del presupuesto del país va a la ciencia, tanto fundamental como aplicada, mucho más que en Argentina en cantidad y porcentaje”.
“Es importante que los líderes sepan que, sin inversión en ciencia, tampoco hay desarrollo industrial. Por eso, es fundamental que la defendamos y expliquemos su importancia. Por ahí, no de una manera confortativa sino comunicando los beneficios que tiene. La mayoría de las decisiones desfavorables que se toman son por ignorancia; entonces, tenemos que ser mejores explicando lo que hacemos”, manifestó el científico.
ANÍBAL BOSCOBOINIK Y LA IMPORTANCIA DE COMPARTIR CONOCIMIENTO
Pese a su residencia en Estados Unidos, Aníbal continúa en contacto con la ciencia argentina y aporta sus experiencias y conocimientos. “El trabajo de este material que tiene unas ‘cajitas’ que atrapan los gases nobles, el último artículo, fue en colaboración con la Universidad de San Luis. Ellos hicieron los cálculos teóricos de cómo se atrapaban los gases. Hemos colaborado bastante”, señaló.
Y agregó: “Argentina tiene colaboraciones con argentinos en el exterior como política de estado, por ley. Una de las patas, es incentivar que los científicos que se fueron vuelvan y otra, que quienes no pueden volver sigan vinculados al sistema científico argentino. Hay 25 redes de científicos conectadas, y funcionamos de manera autónoma. Trabajamos para defender la ciencia argentina en tiempos difíciles, como los de ahora”.

Consultado por las metas que persigue a nivel científico, el dolorense dejó de lado su personalismo y apuntó y apostó a la difusión de esta pasión. “Busco inspirar a gente joven para que siga el camino de la ciencia, y que sepa que los conocimientos pueden aplicarse para un beneficio social”, reflexionó.